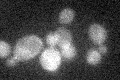
YML058W-A
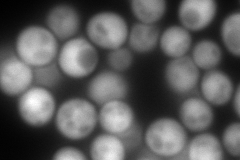
YML058W-A
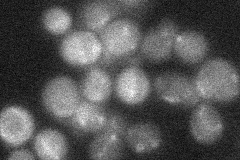
YML058W-A
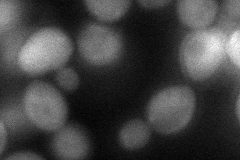
YML058W-A
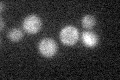
YML058W-A

View description
Protein involved in the Mec1p-mediated checkpoint pathway that responds to DNA damage or replication arrest, transcription is induced by DNA damage
Localization:
Intensity:
Fold change:
Significance:
-
C’ GFP library in SD
below threshold19.66 -
N' NOP1pr-GFP in SD

cytosol369.018 -
N' TEF2pr-mCherry in SD
cytosol511.94 -
N' NATIVEpr-GFP in SD
below threshold22.2121 -
N' TEF2pr-VC and Cyto-VN in SD
cytosol61.4565 -
C’ GFP library in SD+DTT

cytosol24.051.22No -
C’ GFP library in SD+H2O2

cytosol23.81.21No -
C’ GFP library in Starvation Media
cytosol25.061.27No -
C’ GFP library on the background of Pup2-DaMP

below threshold -
C’ GFP library on the background of CCT mutant

below threshold17.50130.889652No
